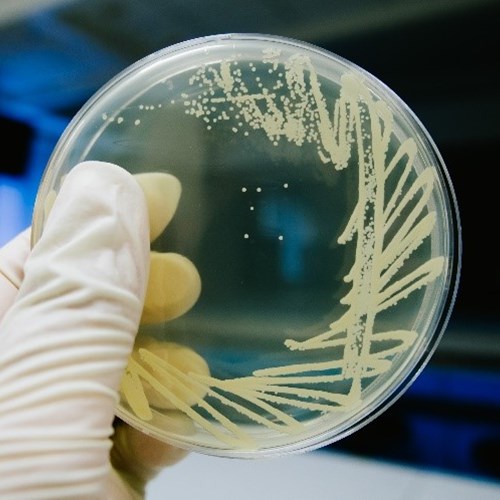
agar plate

Seafood Safety
Welcome to Cefas’ International Centre of Excellence for Seafood Safety.
Working across the globe to support safe and sustainable seafood.
The Centre is founded on our wealth of experience in delivering Official Control programmes for Government, knowledge of regulatory frameworks, National and International Reference Centre designations, advice and analysis. Our team of world leading, specialist scientists apply their in-depth knowledge to support global safe trade in seafood products. You can find out more about our work in the UK and internationally with others through ‘Our FAO Reference Centres and Other Designations’ or contact the Director of the Centre, Wendy Higman.
Click below to see more information on our collaborations and network